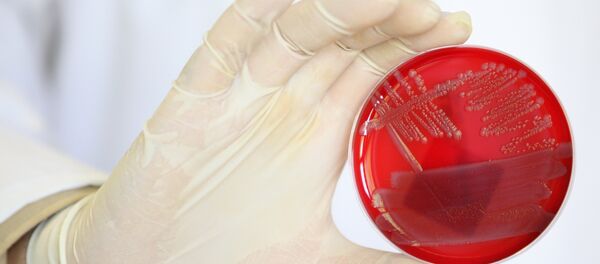
Colonias de bacterias E.Coli - Sputnik Mundo

Unos 200 casos de la enfermedad se detectaron la semana pasada en Helsinki, Espoo, Vantaa y Kauniainen.
"Pedimos a los ciudadanos tomar en cuenta esta circunstancia a la hora de planificar sus viajes", dijeron los responsables de la oficina sanitaria rusa.
Además precisaron que los especialistas de Finlandia sospechan que el origen está en las hojas de rúcula.
Los enfermos contagiados con la bacteria E.coli enterohemorrágica (ECEH) presentan vómitos, diarrea y dolores de cabeza.